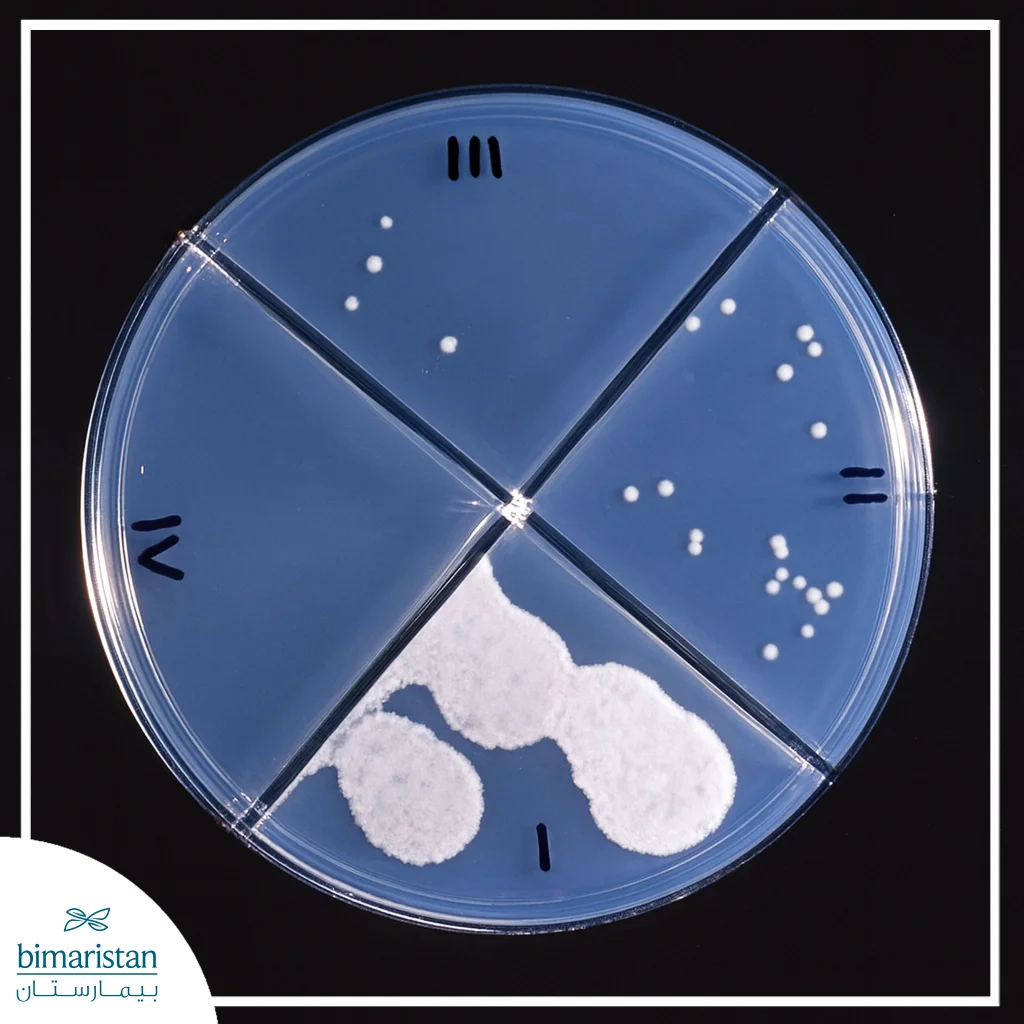
السل المقاوم للأدوية: الأسباب، الأعراض، والعلاج الحديث 4 طبق مخبري يُظهر نمو جراثيم السل المقاوم للأدوية في اختبار الحساسية

يُعدّ السل من الأمراض التي يمكن علاجها والشفاء منها عادةً عند الالتزام بالأدوية المقررة، إلا أنّ بعض الحالات تشهد تطوّر مقاومة ضد هذه الأدوية، مما يجعل السيطرة على المرض أكثر تعقيداً. يُعرف هذا النوع باسم السل المقاوم للأدوية، وهو أحد أخطر التحديات التي تواجه أنظمة الصحة العامة حول العالم.
تشير تقديرات منظمة الصحة العالمية إلى إصابة مئات الآلاف سنوياً بهذه السلالة، مما يزيد العبء على المراكز الصحية والبرامج العلاجية في الدول منخفضة ومتوسطة الدخل. يؤدي ظهور المقاومة الدوائية إلى انخفاض فعالية العلاج التقليدي وازدياد معدلات الانتكاس والوفاة، مما يستدعي اعتماد أنظمة علاجية طويلة الأمد ومراقبة دقيقة لضمان السيطرة على العدوى والحد من انتشارها.
ما هو السل المقاوم للأدوية؟
يحدث السل المقاوم للأدوية عندما تصبح جرثومة المتفطرة السلًية غير حساسة تجاه واحد أو أكثر من الأدوية الفعالة المستخدمة عادة في علاج السل، تنتقل العدوى بالطريقة نفسها التي ينتقل بها مرض السل العادي عبر الرذاذ المتطاير من الشخص المصاب، إلا أنّ تأخر اكتشاف المقاومة أو تأخر الوصول إلى العلاج المناسب يؤدي إلى زيادة انتشار العدوى وظهور سلالات جديدة أكثر مقاومة.
يُعدّ هذا الشكل من المرض تهديداً متزايداً للصحة العامة في العديد من الدول، حيث ارتفع خلال السنوات الأخيرة عدد الإصابات بالجراثيم المقاومة لأكثر الأدوية فعالية مثل الإيزونيازيد والريفامبيسين، ويُسبب السل المقاوم للأدوية معدلات أعلى من المضاعفات والوفيات إضافةً إلى الحاجة لعلاجات أطول وأكثر كلفة وتعقيداً، مما يجعل السيطرة عليه تحدياً حقيقياً يتطلب تشخيصاً دقيقاً وإشرافاً طبياً متخصصاً.
أنواع السل المقاوم للأدوية
تتعدد أشكال السل المقاوم للأدوية تبعاً لعدد ونوع العقاقير التي تفقد فعاليتها ضد جرثومة السل، وتشمل:
- السل أحادي المقاومة: يحدث عندما تُظهر الجرثومة مقاومة تجاه دواء واحد فقط من أدوية علاج السل.
- السل متعدد المقاومة الجزئية: ينشأ عندما تكون الجرثومة مقاومة لدواءين أو أكثر من أدوية السل، بشرط ألا يكون كلاهما الإيزونيازيد والريفامبيسين معاً.
- السل المقاوم للأدوية المتعددة (MDR-TB)
- السل شبه الشديد المقاومة (Pre-XDR-TB): يُعدّ شكلاً متقدماً من الـ MDR-TB، وتكون الجرثومة فيه مقاومة للإيزونيازيد والريفامبيسين بالإضافة إلى أحد أدوية الفلوروكينولون، أو أحد أدوية الحقن من الخط الثاني مثل الأميكاسين أو الكانامايسين أو الكابريومايسين.
- السل الشديد المقاومة (XDR-TB)
تُعدّ هذه الأنواع من السل مشكلة متنامية عالمياً، إذ يؤدي الانتشار المستمر للسلالات المقاومة إلى صعوبة السيطرة على المرض وارتفاع الحاجة إلى أدوية جديدة قادرة على تجاوز المقاومة المتزايدة، وفيما يلي توضيح لأهم هذه الأنواع وأكثرها شيوعاً وانتشاراً:
السل المقاوم للأدوية المتعددة (MDR-TB)
يُعدّ السل المقاوم للأدوية المتعددة (MDR-TB) أكثر أشكال السل المقاوم انتشاراً، وينشأ عندما تكتسب جرثومة المتفطرة السلَية مقاومة تجاه اثنين من أهم أدوية الخط الأول، وهما الإيزونيازيد والريفامبيسين. يحدث السل المقاوم للأدوية المتعددة غالباً نتيجة أخطاء بشرية أثناء العلاج، مثل وصف الأدوية بطريقة غير مناسبة، أو ضعف جودة العقاقير، أو انقطاع المريض عن تناولها قبل إتمام المدة المقررة، كما يساهم غياب برامج وطنية فعالة للسيطرة على السل وضعف الإشراف الطبي في ازدياد معدلات الإصابة وانتقال العدوى داخل المجتمع.
تتشابه أعراض MDR-TB مع أعراض السل العادي وتشمل السعال المزمن، ونقص الوزن، والتعب العام، والحمى الخفيفة، إلا أنَ المرض يستمر لفترة أطول بسبب بطء استجابة الجرثومة أو عدم تأثرها بالعلاج المعتاد. ينتشر هذا الشكل في معظم مناطق العالم، وتتركز النسب الأعلى في الصين والهند وبلدان أوروبا الشرقية وآسيا الوسطى وفق تقديرات منظمة الصحة العالمية.
يتطلّب علاج MDR-TB استخدام أدوية الخط الثاني مثل الفلوروكينولونات وأدوية الحقن (كالأميكاسين أو الكابريومايسين) بالإضافة إلى أدوية أخرى مثل Linezolid وClofazimine وCycloserine، وقد يُضاف Bedaquiline أو Delamanid في الحالات الصعبة. يستمر العلاج عادة من 18 إلى 24 شهراً ويحتاج إلى متابعة دقيقة لتجنّب الآثار الجانبية وضمان الالتزام الكامل بالخطة العلاجية.
السل الشديد المقاومة (XDR-TB)
يُعدّ السل الشديد المقاومة (XDR-TB) الشكل الأكثر تعقيداً وخطورة ضمن طيف السل المقاوم للأدوية. في هذا النوع، تفقد الجرثومة حساسيتها تجاه الريفامبيسين وأحد أدوية الفلوروكينولون، بالإضافة إلى دواء آخر من الفئة الحديثة ذات الأولوية مثل Bedaquiline أو Linezolid، مما يجعل خيارات العلاج محدودة وصعوبة الشفاء أكبر.
تُعدّ مقاومة هذا النوع من السل ناتجة غالباً عن تطوّر غير مُسيطر عليه لحالات السل المقاوم للأدوية المتعددة عند استخدام الأدوية بطريقة غير مناسبة أو عند عدم الالتزام بالعلاج لفترات طويلة. ولهذا السبب، يُعتبر XDR-TB مرحلة متقدمة من المقاومة الدوائية تتطلب تشخيصاً مبكراً لمنع انتقالها للمجتمع.
تُظهر الدراسات أنّ فرص التعافي من XDR-TB أقل من الحالات الأخرى، إذ تتراوح نسب الشفاء بين 40% و60% فقط حسب توفر الأدوية الحديثة وإمكانيات المتابعة. العلاج في هذه الحالات يعتمد على أنظمة علاجية فردية تُصمَّم بعد إجراء اختبار الحساسية الدوائية لكل مريض، مع مراقبة دقيقة للآثار الجانبية مثل السمية الكبدية والعصبية. كما يُوصى بإدارة هذه الحالات حصراً في مراكز طبية متخصصة تضم فرقاً خبيرة في علاج السل المقاوم للأدوية، مع توفير دعم نفسي وغذائي مستمر للمريض لضمان التزامه بالخطة العلاجية المعقدة والطويلة.
أسباب ظهور السل المقاوم للأدوية
يتطوّر السل المقاوم للأدوية بطريقتين رئيسيتين تبعاً لآلية نشوء المقاومة وانتقالها بين الأفراد:
- المقاومة الأولية: تحدث عندما تنتقل جراثيم المتفطرة السلَية المقاومة للأدوية من شخص مصاب إلى شخص سليم، أي أن المريض يُصاب منذ البداية بسلالة مقاومة دون أن يتعرض للعلاج سابقاً. يُعدّ هذا النوع مؤشراً خطيراً على انتشار العدوى داخل المجتمع وصعوبة السيطرة عليها.
- المقاومة الثانوية أو المكتسبة: تنشأ خلال فترة علاج السل نتيجة أخطاء بشرية أو مشكلات علاجية، وتشمل:
- استخدام نظام علاجي غير مناسب أو جرعات دوائية غير كافية
- انقطاع المريض عن العلاج أو تناوله للأدوية بطريقة غير منتظمة
- ضعف امتصاص الجسم للعقار أو تداخل الأدوية مما يقلل فعاليتها
- تدني جودة الأدوية أو غياب الإشراف الطبي الدقيق على المرضى
تؤدي هذه العوامل مجتمعة إلى إتاحة الفرصة للجراثيم لتطوير طفرات جينية جديدة تمنحها القدرة على مقاومة الأدوية، مما يزيد من صعوبة العلاج وانتشار العدوى داخل المجتمع.
تأثير فيروس HIV على مقاومة مرض السل للأدوية
يُعدّ التفاعل بين فيروس نقص المناعة البشرية (HIV) ومرض السل من أكثر العوامل التي تعقّد السيطرة على العدوى في الدول النامية، فالإصابة بفيروس HIV تُضعف الجهاز المناعي بشدة مما يجعل الجسم أقل قدرة على مقاومة جرثومة السل أو التخلص منها حتى أثناء العلاج. يؤدي هذا الضعف المناعي إلى ارتفاع احتمالية تطور المقاومة الدوائية، إذ تصبح الجراثيم قادرة على البقاء لفترات أطول داخل الجسم والتعرض المتكرر للأدوية دون القضاء التام عليها، كما أن المرضى المصابين بـHIV غالباً ما يواجهون صعوبة في الالتزام بالعلاج نتيجة الآثار الجانبية أو التداخلات بين أدوية السل وأدوية الفيروس، مما يزيد من خطر ظهور سلالات مقاومة.
تشير الإحصائيات إلى أن معدلات السل المقاوم للأدوية المتعددة (MDR-TB) أعلى بوضوح بين المصابين بفيروس HIV، خصوصاً في مناطق إفريقيا جنوب الصحراء الكبرى وجنوب شرق آسيا، حيث تتداخل العدوى بشكل واسع. لذلك تؤكد منظمة الصحة العالمية على أهمية دمج برامج علاج السل مع برامج مكافحة HIV لضمان التشخيص المبكر وتنسيق العلاج بشكل يمنع تطور المقاومة ويحد من انتشارها.
تشخيص السل المقاوم للأدوية
يُعدّ تشخيص السل المقاوم للأدوية خطوة أساسية لتحديد الخطة العلاجية المناسبة لكل مريض، إذ لا يمكن التأكد من وجود المقاومة إلا من خلال اختبارات الحساسية الدوائية التي تكشف مدى استجابة جرثومة السل للأدوية المختلفة. تساعد نتائج هذه الفحوص الأطباء على اختيار الأدوية الفعالة وتجنّب استخدام الأدوية التي فقدت تأثيرها. تعتمد المختبرات الطبية الحديثة على نوعين رئيسيين من الاختبارات:
- الاختبارات الجزيئية السريعة: تكشف هذه الفحوص عن الطفرات الجينية المسؤولة عن مقاومة الجرثومة للأدوية، ويمكن إجراؤها مباشرة على عينات البلغم دون انتظار الزرع المخبري، وتُظهر النتائج عادة خلال ساعات قليلة فقط، إذ يمكن أن يعطي فحص GeneXpert المعتمد من منظمة الصحة العالمية نتيجة دقيقة خلال نحو ساعتين، مما يتيح البدء بالعلاج المناسب بسرعة.
- الاختبارات المعتمدة على الزرع: تعتمد على زرع جرثومة السل في أوساط خاصة تحتوي على الأدوية المضادة، فإذا استمرت الجراثيم بالنمو تُعتبر مقاومة لذلك الدواء. تُعد هذه الطريقة أكثر دقة لكنها تحتاج وقتاً أطول قد يصل إلى 3 أسابيع.
في حال لم يتحسن المريض بعد ثلاثة أشهر من العلاج أو بقيت نتائج الزرع إيجابية، يجب إعادة اختبار الحساسية لتقييم فعالية الأدوية المستخدمة، أما فحوص الأدوية من الخط الثاني فيُجرى تنفيذها حصراً في المختبرات المرجعية المتخصصة لضمان الدقة والأمان. تُسهم هذه التقنيات الحديثة في الكشف المبكر عن المقاومة الدوائية وتساعد على منع انتشار العدوى من المرضى غير المستجيبين للعلاج التقليدي.
علاج السل المقاوم للأدوية
يُعدّ علاج السل المقاوم للأدوية من أكثر مراحل التعامل مع المرض تعقيداً، إذ يتطلّب إشرافاً طبياً دقيقاً ومتابعة مستمرة لضمان القضاء على الجرثومة ومنع تطور مقاومة إضافية. يعتمد نجاح العلاج على معرفة الأدوية التي لا تزال فعّالة ضد السلالة المسببة للمرض، لذلك تُبنى الخطة العلاجية على نتائج اختبار الحساسية الدوائية لكل مريض على حدة.
يُعالج المصابون عادة ضمن برامج خاصة تُعرف باسم العلاج تحت المراقبة المباشرة المتقدمة (DOTS-Plus)، وهي النسخة المخصصة من برنامج DOT المستخدم لعلاج السل الحساس للأدوية. في هذا النظام يتابع الكادر الصحي المريض يومياً للتأكد من تناول الأدوية بانتظام، ما يقلل من احتمالية الانتكاس أو فشل العلاج ويحد من انتقال العدوى داخل المجتمع. كما يُوصى بأن تتم متابعة المرضى داخل مراكز متخصصة قادرة على رصد الآثار الجانبية ومراقبة تطور الاستجابة العلاجية بشكل دوري.

أدوية الخط الثاني
بخلاف علاج السل التقليدي الذي يعتمد على أدوية الخط الأول لمدة تقارب ستة أشهر، تتطلّب الحالات المقاومة خطة علاجية أطول وأكثر تعقيداً، فعندما تفقد الأدوية الأساسية مثل الإيزونيازيد والريفامبيسين فعاليتها، يلجأ الأطباء إلى استخدام أدوية الخط الثاني التي تشمل مجموعة من العقاقير الفموية والحقنية ذات التأثير الأقوى ولكنها تحتاج إلى متابعة دقيقة بسبب آثارها الجانبية المحتملة.
- أدوية الفلوروكينولون (مثل Levofloxacin وMoxifloxacin)
- أدوية الحقن (مثل Amikacin وCapreomycin)
- أدوية فموية أخرى مثل Linezolid وClofazimine وCycloserine وEthionamide وPyrazinamide
تُختار الأدوية بناءً على نتائج الاختبارات، ويستمر العلاج عادة لمدة تتراوح بين 18 و24 شهراً مع مراقبة دقيقة للسمية الكبدية والعصبية والسمعية.
العلاجات الحديثة قصيرة المدى
تشير التوصيات الحديثة الصادرة عام 2025 إلى اعتماد أنظمة علاجية أقصر وأكثر أماناً تعتمد بالكامل على الأدوية الفموية، دون الحاجة إلى الحقن. ومن أبرز هذه الأنظمة:
- النظام BPaL (يضم Bedaquiline + Pretomanid + Linezolid)
- النظام BPaLM (نفس التركيبة مع Moxifloxacin)
أثبتت الدراسات أنّ هذه الأنظمة تقلل مدة العلاج إلى نحو 9 أشهر فقط مع نسب شفاء تتجاوز 85 ٪ في بعض المراكز مقارنة بالعلاجات التقليدية الطويلة.
المتابعة والعزل الوقائي
في المراحل الأولى من العلاج، يُوصى عادةً بعزل المريض مؤقتاً في مستشفى أو قسم مخصص حتى تُظهر التحاليل المخبرية أن البلغم أصبح سلبياً وغير معدٍ. يهدف هذا الإجراء إلى الحد من انتشار السلالات المقاومة داخل المجتمع وحماية أفراد العائلة والمخالطين، ويُعتبر الالتزام الصارم بالأدوية والمتابعة الطبية المنتظمة أمراً أساسياً لضمان نجاح العلاج، إذ يُجري الأطباء فحوصاً شهرية للكبد والدم لمراقبة السمية الناتجة عن الأدوية وضبط الجرعات عند الحاجة، كما يُقدَّم للمريض دعم نفسي وغذائي مستمر يساعده على تحمّل فترة العلاج الطويلة والالتزام بها حتى الشفاء التام.
مضاعفات وتأثيرات السل المقاوم للأدوية
يُعدّ السل المقاوم للأدوية من أخطر أنواع العدوى المزمنة، إذ يسبب أضراراً دائمة في الرئتين نتيجة الالتهاب المستمر وتكوّن الندبات الليفية، مما يضعف القدرة التنفسية حتى بعد الشفاء. وفي بعض الحالات قد تمتد العدوى إلى أعضاء أخرى كالعظام أو الكليتين.
يُرافق العلاج الطويل خطر حدوث آثار جانبية دوائية مثل السمية الكبدية والعصبية واضطرابات السمع أو البصر، إلى جانب الإرهاق النفسي الناتج عن طول فترة العلاج. كما يمثل المرض عبئاً اقتصادياً على المريض والمجتمع نظراً لتكاليف الأدوية المرتفعة وطول مدة المتابعة الطبية.
الوقاية من انتشار السل المقاوم للأدوية
تبدأ الوقاية من السل المقاوم للأدوية بالحد من التعرض لجراثيم السل المنتقلة من المرضى المصابين، خاصة في الأماكن المغلقة أو المزدحمة، لذلك يُنصح العاملون في المستشفيات أو المراكز التي تُعالج حالات السل باستشارة مختصي مكافحة العدوى، واتباع إجراءات السلامة مثل تهوية الغرف الجيدة واستخدام الكمامات الواقية عند التعامل مع المرضى.
أما الوقاية من المقاومة الثانوية المكتسبة فتتحقق من خلال الالتزام الصارم بالعلاج وتناول جميع الأدوية في مواعيدها المحددة دون انقطاع، إذ إن التوقف المبكر أو نسيان الجرعات يسمح للجراثيم بالبقاء والتطور لتصبح أكثر مقاومة. يساعد الكادر الطبي في الوقاية عبر تشخيص الحالات مبكراً، وإجراء اختبارات الحساسية الدوائية لتحديد العلاج الأنسب، ومتابعة استجابة المريض للعلاج بشكل دوري حتى إتمام الشفاء. كما تسهم برامج العلاج تحت المراقبة المباشرة في ضمان الالتزام الكامل ومنع فشل العلاج أو تطور مقاومة جديدة.
في الختام، يُعدّ السل المقاوم للأدوية من أخطر التحديات التي تواجه الطب الحديث، إذ يتطلب علاجاً طويلاً وإشرافاً دقيقاً لضمان الشفاء الكامل ومنع انتشار السلالات المقاومة، ومع تطور الأدوية الحديثة وبرامج المتابعة الصارمة ارتفعت معدلات الشفاء وأصبحت فرص السيطرة على المرض أفضل من السابق. يوفّر مركز بيمارستان الطبي للمرضى في تركيا خدمات استشارية متكاملة وتوجيهاً نحو المراكز المتخصصة بعلاج حالات السل المعقدة بأحدث البروتوكولات العالمية، ليحصل المرضى على الرعاية الأفضل في بيئة آمنة ومتقدمة.
المصادر:
- Centers for Disease Control and Prevention. (2025, January 6). Clinical overview of drug-resistant tuberculosis disease.
- American Thoracic Society, U.S. Centers for Disease Control and Prevention, European Respiratory Society, & Infectious Diseases Society of America. (2019). Treatment of drug-resistant tuberculosis: An official ATS/CDC/ERS/IDSA clinical practice guideline. American Journal of Respiratory and Critical Care Medicine, 200(10), e93–e142. https://doi.org/10.1164/rccm.201909-1874ST
